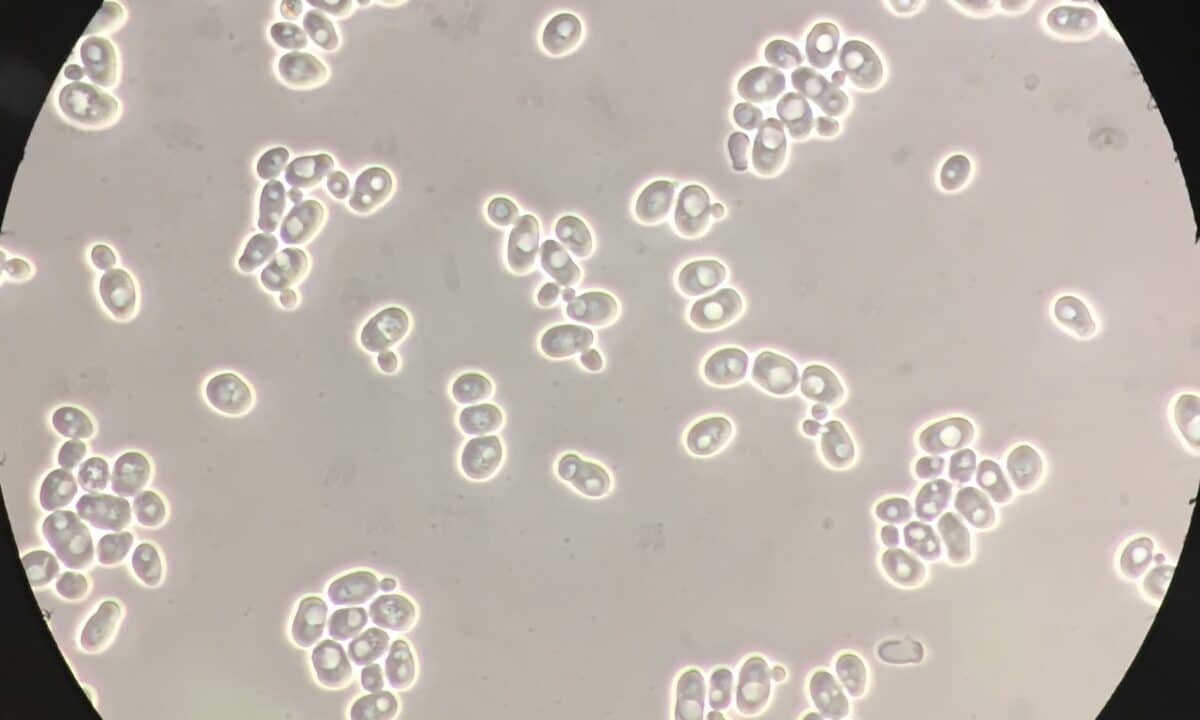

with Andrew McDiarmid




Andrew McDiarmid interviews astrophysicist Dr. Sarah Salviander on finding God on scientific grounds.
…
Stephen C. Meyer joins Michael to discuss the scientific case for intelligent design. Drawing from Signature in the Cell and Darwin’s Doubt, Meyer presents evidence from molecular biology, the Cambrian explosion, and information theory that challenges unguided Darwinian evolution and points to an intelligent cause. He addresses common objections and explores the implications for science and worldview. A clear, evidence-based look at one of today’s most important debates.
…
Sean McDowell interviews Dr. Jay Richards about the origin of life and the fine-tuning argument.
…























































































